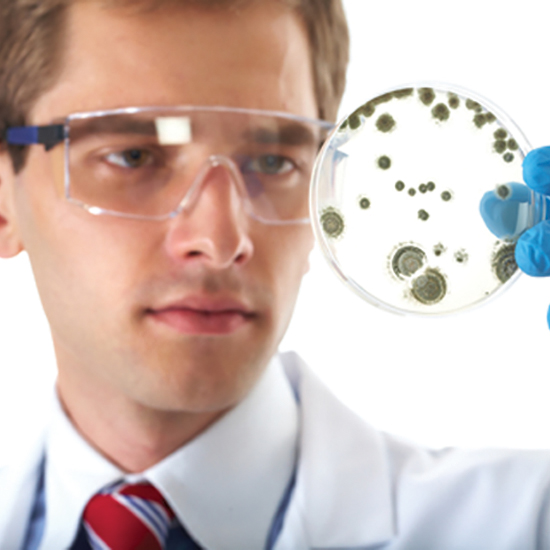

Раціональне використання антибіотиків у сучасному світі. Antibiotic resistance STOP!
Шановні колеги!
Запрошуємо вас узяти участь у І Міжнародному конгресі «Раціональне використання антибіотиків у сучасному світі. Antibiotic resistance STOP!», який відбудеться 15–16 листопада 2018 р. у Києві під час Всесвітнього тижня належного застосування антибіотиків.
Запрошуємо вас узяти участь у І Міжнародному конгресі «Раціональне використання антибіотиків у сучасному світі. Antibiotic resistance STOP!», який відбудеться 15–16 листопада 2018 р. у Києві під час Всесвітнього тижня належного застосування антибіотиків.
Для кого захід
Захід об’єднає фахівців різних спеціальностей, які будуть обговорювати проблеми зниження ефективності дії антибіотиків та пошуку нових підходів у боротьбі з антибіотикорезистентністю. Основна мета конгресу — обмін досвідом, сприяння підвищенню компетентності медичних працівників з питань належного застосування антибіотиків у практичній діяльності та покращення надання медичної допомоги хворим. Учасники конгресу будуть забезпечені максимальною кількістю міжнародних кредитів — 14 AMA PRA Category 1 CreditsТМ.
Організатори
Конгрес включено до Реєстру (під № 19) з’їздів, конгресів, симпозіумів та науково-практичних конференцій на 2018 рік, який затверджений Міністерством охорони здоров’я України, Національною академією медичних наук України та Українським центром наукової медичної інформації та патентно-ліцензійної роботи МОЗ України.
Контакти організаторів:
Тел.: +380 (96) 338-65-75
Е-mail: [email protected]
Сайт: antibiotic-congress.com
Читайте також «Роль лікаря первинки у подоланні антибіотикорезистентності».
Прес-служба «Українського медичного часопису»
за матеріалами організаторів заходу





